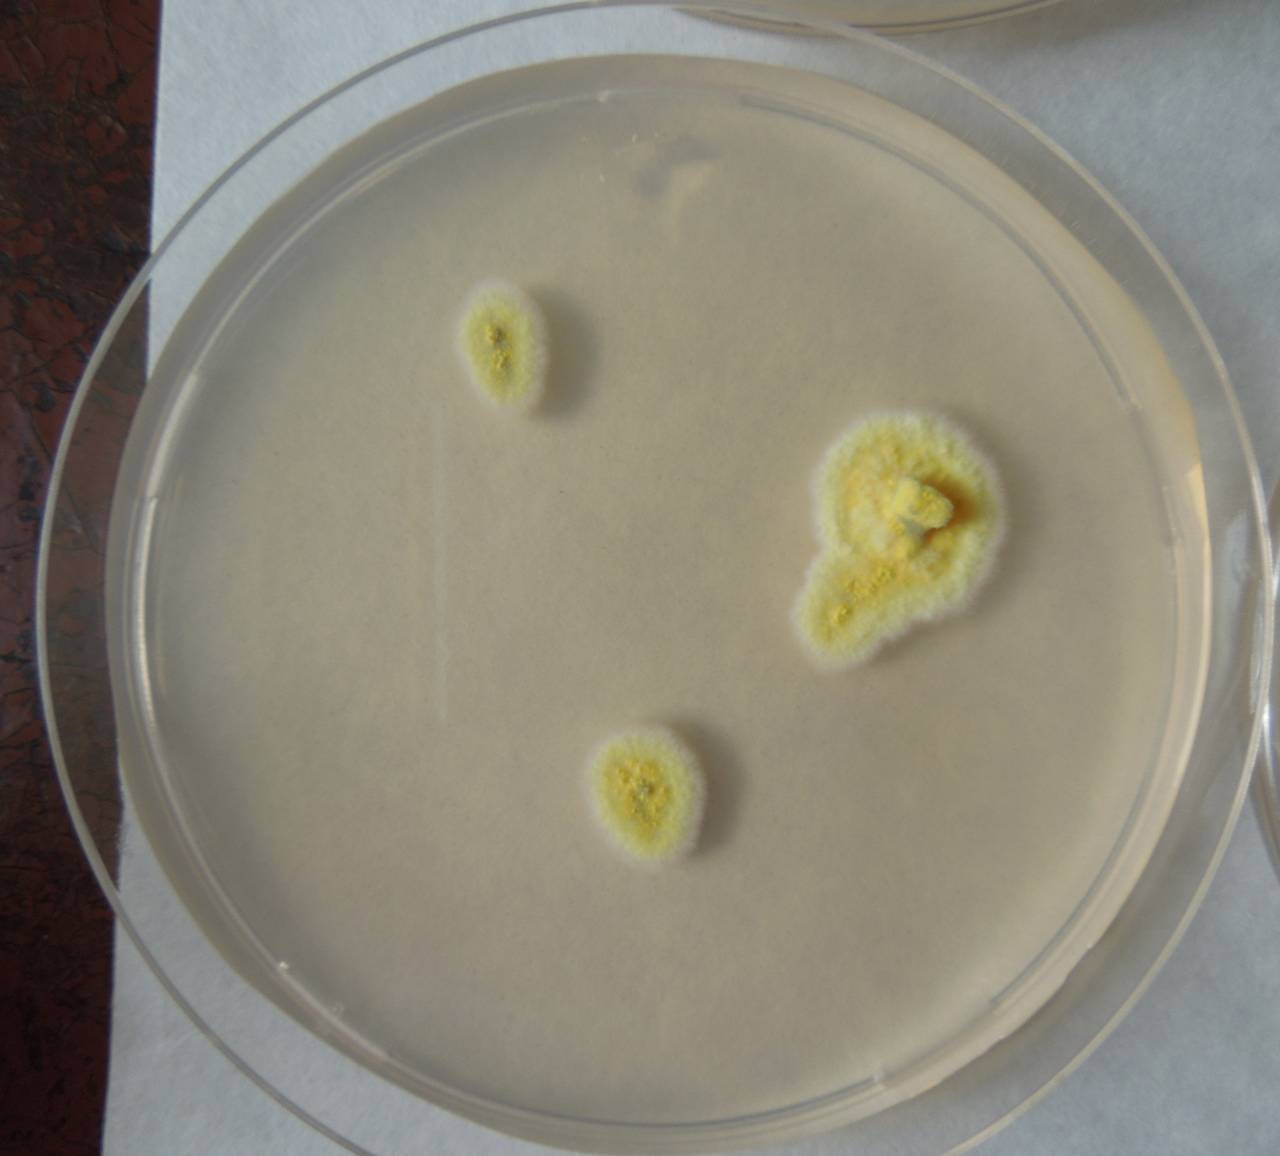
MSU_FS-01853, Район Бу Зяп (Bù Gia Mập district), Bình Phước province (Vietnam)

Full image

Licensed under CC-BY 4.0 (see recommended citation in "Full record" following "How to cite" link)
Do you want to join the team of "Distribution Atlas of the Russian Flora"? Upload your photos of plants in wild with exact location on iNaturalist to contribute our new project "Флора России | Flora of Russia".
- Specimen ID
- 0000000904808
- Species
- Talaromyces wortmannii
- Strain
- MSU_FS-01853
- Place of isolation
- Район Бу Зяп (Bù Gia Mập district), Bình Phước province (Vietnam)
- Placename
- Бу Зя Мап (Bù Gia Mập)
All specimens of the species